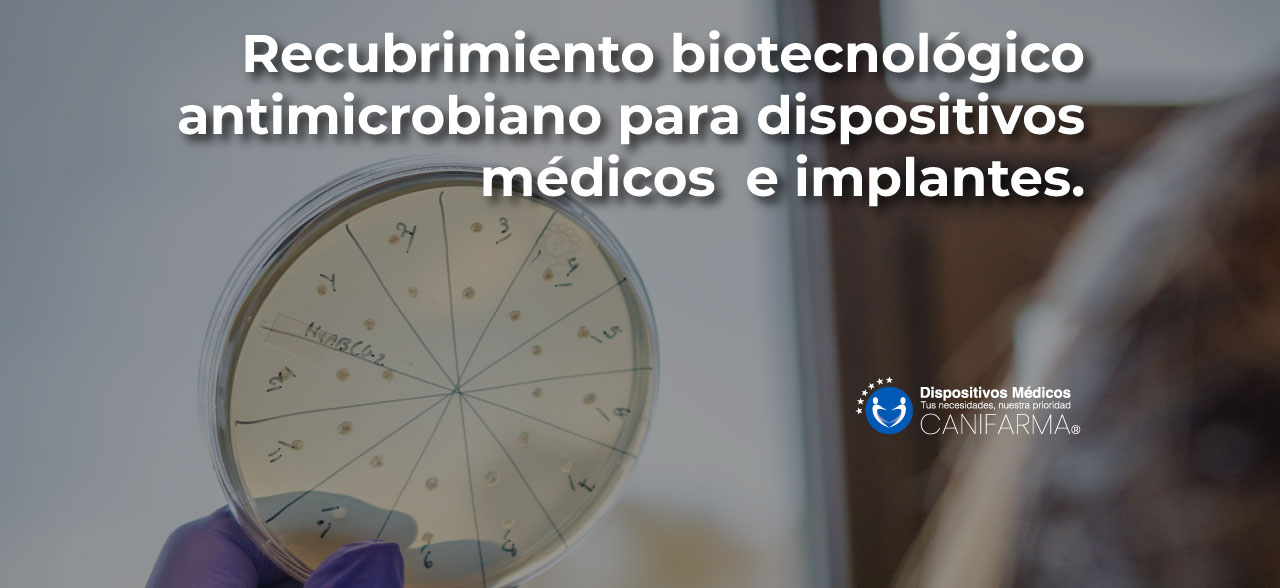

Una nueva tecnología de recubrimiento para dispositivos médicos que representa un cambio de paradigma en la prevención de infecciones y la protección contra una amplia gama de patógenos. Incorpora componentes activos y pasivos para crear un revestimiento antimicrobiano duradero, seguro, eficaz y que no se filtra para dispositivos médicos e implantes.
La Organización Mundial de la Salud estima que las infecciones asociadas a la atención médica, especialmente aquellas causadas por patógenos resistentes a los antimicrobianos, son el evento adverso que ocurre con mayor frecuencia en cualquier sistema de atención médica, independientemente de los recursos disponibles. En los servicios de salud modernos se emplean muchos tipos de dispositivos médicos, invasivos y no invasivos, para tratar a los pacientes y ayudarles a recuperarse. Estos dispositivos médicos provocan más del 50% de las infecciones iatrogénicas, lo cual genera unos gastos imprevistos de miles de millones de euros para los sistemas sanitarios de todo el mundo.
Los estrictos regímenes de higiene y los desinfectantes existentes tienen una eficacia limitada para reducir el riesgo de infección durante períodos prolongados de tiempo. Gracias a los avances en biotecnología se ha desarrollado un nuevo recubrimiento que brinda protección monoclonal y que además elimina un amplio espectro de grampositivos. y bacterias gramnegativas, así como virus envueltos y no envueltos, incluidos E.Coli, MRSA, Influenza, Norovirus y SARS-Cov-2. BioInteractions, una empresa de tecnología de biomateriales del Reino Unido, ha lanzado TridAnt, adecuado para la protección de la piel, así como para la mayoría de las demás superficies, incluidas las telas tejidas y no tejidas, incluidos los metales (nitinol), así como los polímeros (policarbonato y poliuretanos).
La nueva tecnología antimicrobiana no se filtra y, por lo tanto, es completamente segura de usar en todos los entornos e incluso para implantes dentro del cuerpo humano. Sus componentes activos se dirigen a los microbios (células procariotas) y tiene un riesgo reducido para las células humanas a diferencia de las tecnologías anteriores. Es la primera tecnología de dispositivo médico conocida que mata virus envueltos, no envueltos y bacterias grampositivas además de gramnegativas, lo que evita la formación de biopelículas durante largos períodos de tiempo de hasta 365 días (así como suficientemente seguro para proteger la piel hasta por 48 horas) sin ninguna reducción notable en la eficacia.
El equipo que desarrolló este tipo de tecnología, también se centró en crear el mejor método de bioingeniería para unir el revestimiento antimicrobiano de forma segura al material de los diferentes dispositivos médicos durante su ciclo de vida. Como resultado, los dispositivos médicos recubiertos con este recubrimiento están protegidos con un escudo altamente efectivo y que no se filtra durante toda la vida útil del dispositivo.
La Dra. Catriona Anderson, médica de cabecera del NHS con experiencia y especialista en el tratamiento de infecciones por microorganismos y bacterias, dijo: «La perspectiva de una tecnología biocompatible que pueda mejorar la función de los dispositivos médicos mediante la eliminación de los microbios existentes y también la prevención de la formación de nuevas colonias representa un cambio de paradigma, en la prevención y tratamiento de infecciones quirúrgicas».